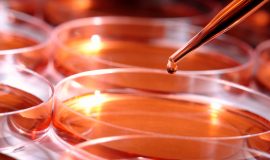
pesquisa nacional

- Associação Nacional de Entidades Promotoras de Empreendimentos Inovadores
Grupo empresarial do BIO-RIO promove palestra
Chamada de Trabalhos: prorrogação até o dia 27
26 de março de 2013Missão 2013: inscrições com desconto até 1/04
26 de março de 2013
A Companhia de Desenvolvimento Industrial do Estado do Rio de Janeiro (Codin), em parceria com o Instituto Brasileiro de Mercado de Capitais (Ibmec), realiza uma palestra sobre biotecnologia no próximo dia 4 de abril. Intitulada “Biotecnologia: Tendências e Oportunidades”, a palestra será ministrada por Eduardo Cruz, presidente da Axis Biotec, grupo empresarial instalado no Polo de Biotecnologia do Rio de Janeiro, o Parque BIO-RIO.
A Companhia de Desenvolvimento Industrial do Estado do Rio de Janeiro (Codin), em parceria com o Instituto Brasileiro de Mercado de Capitais (Ibmec), realiza uma palestra sobre biotecnologia no próximo dia 4 de abril. Intitulada “Biotecnologia: Tendências e Oportunidades”, a palestra será ministrada por Eduardo Cruz, presidente da Axis Biotec, grupo empresarial instalado no Polo de Biotecnologia do Rio de Janeiro, o Parque BIO-RIO.
O encontro tem início às 18h, no Auditório do IBMEC Unidade Centro, na Avenida Presidente Wilson, 118, 10º andar. A Codin é administrada pelo Governo do Estado do Rio de Janeiro e o objetivo do encontro é disseminar informações estratégicas sobre o setor de biotecnologia em sinergia com o novo ciclo de desenvolvimento econômico do estado. Interessados em participar da palestra, devem enviar email para [email protected], informando nome, empresa e telefone para contato.
*Com informações da Codin






